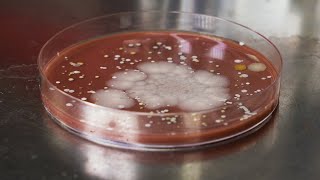

20 Second Hand Washing The Science behind it and why it WORKS! video
Online izle ve mp4 mp3 formatlarinda yukle

Videonun muddeti: 2:16
20 Second Hand Washing The Science behind it and why it WORKS! videosu mp4 ve mp3 yuklemek ucun hazirdir
Diqqet! Siz Mp4 yukle ve ya Mp3 yukle duymesine basdiqdan sonra eger sistem sizi reklam sehifesine atarsa o zaman derhal geri qayidib emeliyyati tekrar edin ve faylin yuklemek ucun hazir olmasini gozleyin
Videodan Mp4 Yukle
Videodan Mp3 Yukle-1
Videodan Mp3 Yukle-2
Oxshar Axtarishlar
 20 Second Hand Washing - The Science behind it and why it WORKS!
20 Second Hand Washing - The Science behind it and why it WORKS! WHO: How to handwash? With soap and water
WHO: How to handwash? With soap and water How does soap work to fight coronavirus? Why wash your hands for 20 seconds?
How does soap work to fight coronavirus? Why wash your hands for 20 seconds? Why do we wash hands for 20 seconds?
Why do we wash hands for 20 seconds? VERIFY: Yes, The 20-Second Hand Washing Rule Does The Trick
VERIFY: Yes, The 20-Second Hand Washing Rule Does The Trick The Science Behind Proper Hand Washing
The Science Behind Proper Hand Washing Why does hand-washing work?
Why does hand-washing work? The CDC says you should wash your hands for 20 seconds. This is why
The CDC says you should wash your hands for 20 seconds. This is why The Right Way to Wash Your Hands for 20 Seconds
The Right Way to Wash Your Hands for 20 Seconds
Video Mp4 Mp3Azwap.Biz
Azwap.Biz 2021-2023


 20 Second Hand Washing - The Science behind it and why it WORKS!
20 Second Hand Washing - The Science behind it and why it WORKS! WHO: How to handwash? With soap and water
WHO: How to handwash? With soap and water How does soap work to fight coronavirus? Why wash your hands for 20 seconds?
How does soap work to fight coronavirus? Why wash your hands for 20 seconds? Why do we wash hands for 20 seconds?
Why do we wash hands for 20 seconds? VERIFY: Yes, The 20-Second Hand Washing Rule Does The Trick
VERIFY: Yes, The 20-Second Hand Washing Rule Does The Trick The Science Behind Proper Hand Washing
The Science Behind Proper Hand Washing Why does hand-washing work?
Why does hand-washing work? The CDC says you should wash your hands for 20 seconds. This is why
The CDC says you should wash your hands for 20 seconds. This is why The Right Way to Wash Your Hands for 20 Seconds
The Right Way to Wash Your Hands for 20 Seconds